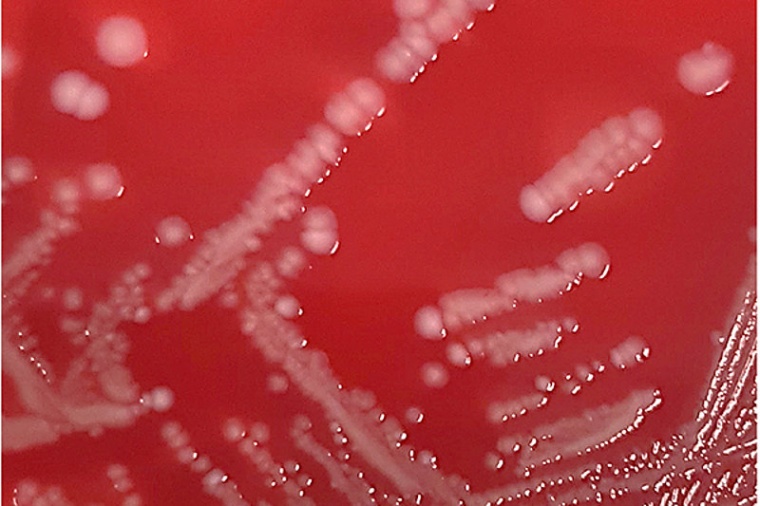
Staphylococcus aureus Kolonien auf Blutagarplatten. Foto: Mukoviszidose e.V.

Mukoviszidose-Forschung: Neue Therapieoptionen bei Infektionen mit dem Problemkeim Staphylococcus aureus erschließen
Dr. Volker Winstel möchte mit seiner Forschung neue Therapieoptionen bei Infektionen mit Staphylococcus aureus erschließen.
Die Behandlung von Infektionen mit der schwer therapierbaren Staphylokokken-Variante SCV (Small Colony Variant) für Menschen mit Mukoviszidose zu verbessern, ist Ziel des neuen Forschungsprojekts der Arbeitsgruppe um Dr. Volker Winstel (Institut für Medizinische Mikrobiologie und Krankenhaushygiene, Medizinische Hochschule Hannover; TWINCORE, Zentrum für Experimentelle und Klinische Infektionsforschung, Hannover). Die Wissenschaftler identifizieren essentielle Wachstumsfaktoren von SCV und testen Hemmstoffe für diese Faktoren auf Wirksamkeit und Verträglichkeit. Dies könnte neue Therapieansätze jenseits der Antibiotikatherapie ermöglichen. Der Mukoviszidose e.V. fördert das Projekt mit 184.065 €. (Mukoviszidose: Cystische Fibrose, CF)
Staphylokokken bei Mukoviszidose-Betroffenen weit verbreitet
Der weitverbreitete Keim Staphylococcus aureus (S. aureus) ist auch bei Mukoviszidose-Patienten einer der am häufigsten isolierte Erreger aus den Atemwegen. S. aureus kann ohne Symptome in der Nase vorkommen, aber auch schwere Lungenentzündungen verursachen und über lange Zeit in den Atemwegen überleben. Eine große Herausforderung bei der Behandlung von Infektionen mit S. aureus sind sowohl seine Fähigkeit, Biofilme zu bilden und sich zu mukoiden Formen zu entwickeln, als auch die Ausbildung verschiedener therapieresistenter Varianten (wie z.B. die Methicillin-resistente Form MRSA).
Besonders schwer zu therapieren: die Variante SCV
Eine weitere schwer zu behandelnde Staphylokokken-Variante ist die kleine Kolonien bildende Variante SCV (Small Colony Variant), die sich entsprechend in der Wuchsform als auch biochemisch von der normalen S. aureus-Variante unterscheiden kann. Diese SCV können auch im Inneren von Zellen (z.B. Lungenepithelzellen) überleben und sich so dem Immunsystem und der medikamentösen Therapie entziehen.
Identifizierung der essentiellen Wachstumsfaktoren von TD-SCV
Die Verbesserung der Therapieoptionen bei Infektionen mit SCV ist ein wichtiges Ziel der Forschung von Winstel und seiner Arbeitsgruppe. Besonders im Fokus haben die Wissenschaftler sogenannte Thymidinabhängige SCVs (TD-SCVs), die durch Antibiotika-Therapie und besonders die Therapie mit Folsäure-Antagonisten entstehen. Im Forschungsprojekt sollen die essentiellen Wachstumsfaktoren der TD-SCVs identifiziert werden, mit denen die Keime ihre Vermehrung und das intrazelluläre Überleben sichern.
Wirksame Antiinfektiva könnten schon bald verfügbar sein
In einem weiteren Schritt untersuchen die Forscher, welche Hemmstoffe an den Wachstumsfaktoren der TD-SCV ansetzen und somit ihre Vermehrung unterbinden und zu einem Absterben der Bakterien führen können. In Vorarbeiten wurde durch die Arbeitsgruppe in einer internationalen Wirkstoff-Datenbank mit zugelassenen Medikamenten bereits nach Hemmstoffen für diese Faktoren gesucht und mögliche neue Therapie-Optionen zur Behandlung der TD-SCVs gefunden. Die identifizierten Medikamente sind keine Antibiotika und würden daher einen neuartigen Therapieansatz darstellen.
Wenn die Wirksamkeit und Verträglichkeit der anvisierten Hemmstoffe in Zellkultur und Tierversuch nachgewiesen werden kann, schafft das Projekt die Grundlage für eine weiterführende klinische Forschung. Da die Wirkstoffe bereits als Medikamente für andere Erkrankungen zugelassen sind, könnten sie als wirksame Antiinfektiva zeitnah zur Verfügung stehen und Mukoviszidose-Betroffenen mit TD-SCV-Infektionen eine wichtige Therapieoption bieten.
Anbieter














